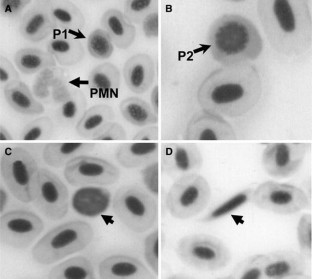

Abstract
Haematological parameters are often used as health status and stress indicators in fish. However, information on the effects of artificial photoperiods on these parameters is scarce and ambiguous. The consequences of three different artificial photoperiod regimes [light/day 12 h:12 h (LD 12:12) for 150 days as controls; LD 14:10 and LD 24:0, both for an initial 60 days, and then LD 12:12 for the remaining 90 days] were evaluated in trout. In all fish the haemogram and the erythrocyte production index (EPI) were assessed at days 7, 14, 30 and 60 (phase 1) and at days 90, 120 and 150 (phase 2). At the end of phase 1, photoperiods LD 14:10 and 24:0 induced higher production of immature (late basophilic) erythrocytes (0.06–0.08 × 1012 cells/l, P < 0.05) and elevated EPI (young erythrocytes = 1.6 in LD 14:10, 2.25 in LD 24:0; late basophilic erythrocytes = 4.1–4.9 in LD 14:10, 3.3 in LD 24:0) than in controls (late basophilic erythrocytes = 0.02–0.04 × 1012 cells/l; EPI young erythrocytes = 0.2–1.0; EPI late basophilic erythrocytes = 1.4–2.7). During phase 2, only reduced numbers of lymphocytes and thrombocytes were observed at day 150 in the LD 14:00 group. An increase in the EPI (1.9) of control young erythrocytes was found at day 150.

Similar content being viewed by others
References
Affonso EG, Polez VLP, Correa CF, Mazon AF, Araujo MRR, Moraes G, Rantin FT (2002) Blood parameters and metabolites in the teleost fish Colossoma macropomum exposed to sulfide or hypoxia. Comp Biochem Physiol 133(C):375–382
Álvarez F, Flaño E, Villena AJ, Zapata A, Razquin BE (1994) Seasonal intrathymic erythropoietic activity in trout. Dev Comp Immunol 18(5):409–420
Ballarin L, Dall’Oro M, Bertotto D, Libertini A, Francescon A, Barbaro A (2004) Haematological parameters in Umbrina cirrosa (Teleostei, Sciaenidae): a comparison between diploid and triploid specimens. Comp Biochem Physiol 138(A):45–51
Bilbo SD, Dhabhar FS, Viswanathan K, Saul A, Nelson RJ (2003) Photoperiod affects the expression of sex and species differences in leukocyte number and leukocyte trafficking in congeneric hamsters. Psychoneuroendocrinology 28:1027–1043
Biswas AK, Maita M, Yoshizaki G, Takeuchi T (2004) Physiological responses in Nile tilapia exposed to different photoperiod regimes. J Fish Biol 65:811–821
Boivin DB, James FO, Wu A, Cho-Park PF, Xiong H, Sun ZS (2003) Circadian clock genes oscillate in human peripheral blood mononuclear cells. Blood 102:4143–4145
Bolliet V, Aranda A, Boujard T (2001) Demand-feeding rhythm in rainbow trout and European catfish. Synchronisation by photoperiod and food availability. Physiol Behav 73:625–633
Bridges D, Cech Jr W, Pedro DH (1976) Seasonal hematological changes in the winter flounder Pseudopleuronectes americanus. Trans Am Fisheries Soc 5:596–600
Bromage N, Porter M, Randall C (2001) The environmental regulation of maturation in farmed finfish with special reference to the role of photoperiod and melatonin. Aquaculture 197:63–98
Campbell TW, Murru F (1990) An introduction to fish hematology. Comp Cont Ed Vet Sci 12:525–533
Cerda-Reverter JM, Zanuy S, Carrillo M, Madrid JA (1998) Time-course studies on plasma glucose, insulin, and cortisol in Sea Bass (Dicentrarchus labrax) held under different photoperiodic regimes. Physiol Behav 64(3):245–250
Collazos ME, Barriga C, Ortega E (1995) Seasonal variations in the immune system of the cyprinid Tinca tinca. Phagocytic function. Comp Immunol Microbiol Infect Dis 18(2):105–113
Collazos ME, Ortega E, Barriga C, Rodríguez B (1998) Seasonal variation in haematological parameters in male and female Tench Tinca tinca. Mol Cell Biochem 114:432–435
Duthie GG, Tort L (1985) Effects of dorsal aortic cannulation on the respiration and haematology of Mediterranean living Scyliorhinus canicula. Comp Biochem Physiol 81(A):879–885
Fange R (1992) Fish blood cells. In: Hoar WS, Randall DJ, Farrell AP (eds) Fish physiology: the cardiovascular system, vol XII (part B) Academic, London
Fijan N (2002) Morphogenesis of blood cell lineages in channel catfish. J Fish Biol 60:999–1014
Gallardo MA, Sala-Rabanal M, Ibarz A, Padro´s F, Blasco J, Fernández-Borra J, Sánchez J (2003) Functional alterations associated with ‘‘winter syndrome’’ in gilthead sea bream (Sparus aurata). Aquaculture 223:15–27
Härdig J, Höglund LB (1984) Seasonal variation in blood components of reared Baltic salmon, Salmo salar L. J Fish Biol 24:565–679
Harris J, Bird DJ (2000) Modulation of the fish immune system by hormones. Vet Immunol Immunopathol 77:163–176
Hero M, Wickman S, Hanhijärvi R, Siimes MA, Dunkel L (2005) Pubertal upregulation of erythropoiesis in boys is determined primarily by androgen. J Pediatr 146(2):245–252
Herrero MJ, Pascual M, Madrid JA, Sánchez-Vázquez FJ (2005) Demand-feeding rhythms and feeding-entrainment of locomotor activity rhythms in tench (Tinca tinca). Physiol Behav 84:595–605
Johnson RW, Arkins S, Dantzer R, Kelley KW (1997) Hormones, lymphohemopoietic cytokines and the neuroimmune axis. Comp Biochem Physiol 116(A):183–201
Kaattari SL, Ottinger CA (2000) Seasonality of trout leukocytic sensitivity to toxicity: implications for immunotoxic biomonitoring. Mar Environ Res 50:465–472
Kenneth W, Beagley, Christine, Gockel M (2003) Regulation of innate and adaptive immunity by the female sex hormones oestradiol and progesterone. FEMS Immunol Med Microbiol 38(1):13–22
Kita J, Itazawa Y (1989) Release of erythrocytes from the spleen during exercise and splenic constriction by adrenaline infusion in the Rainbow trout. Jpn J Ichthyol 36(1):48–52
Kita J, Itazawa Y (1990) Effects of adrenaline on the blood flow through the spleen of rainbow trout (Salmo gairdneri). Comp Biochem Physiol 95A(4):591–595
Klontz G W (1994) Fish hematology. In: Stolen JD, Rowley AF, Zelikoff JT, Kaatari SL, Smith SA (eds) Techniques in fish immunology. FITC 3 SOS Publications, Fair Haven, USA, pp 121–131
Korzhuev PA, Alyakrinskava IO, Dolgova SN (1982) Characteristics of the blood in young and adult Salmo salar (Salmonidae). J Ichthyol 22:112–1120
Lane HC (1979) Progressive changes in the haematology and tissue water of sexually mature trout, Salmo gairdneri Richardson during the autumn and winter. J Fish Biol 15:425–436
Leonardi MO, Klempau AE (2003) Artificial photoperiod influence on the immune system of juvenile rainbow trout (Oncorhynchus mykiss) in the southern hemisphere. Aquaculture 221:581–591
Leu SL, Shiah IS, Yatham LN, Cheu YM, Lam RW (2001) Immune-inflammatory markers in patients with seasonal affective disorder: effects of light therapy. J Affect Disorders 63:27–34
Melingen GO, Pettersen EF, Wergeland HI (2002) Leucocyte populations and response to immunization and photoperiod manipulation in Atlantic salmon (Salmo salar L) 0 + smolt. Aquaculture 214:381–396
Nakanishi T (1986) Seasonal changes in the humoral immune response and the lymphoid tissues of the marine teleost Sebastiscus marmoratus. Vet Immunol Immunopathol 12:213–221
Ohno Y., Fisher JW (1978) Effects of androgens on burst forming units (BFU-E) in normal rabbit bone marrows. Life Sci 22:2031–2036
Orrego R, Moraga G, Gonzalez M, Gavilán JF, Valenzuela A, Burgos A, Barra R (2005) Reproductive, physiological and biochemical responses in juvenile female rainbow trout (Oncorhynchus mykiss) exposed to sediment from pulp and paper mill industrial discharge areas. Environ Toxicol Chem 24(8):1935–1943
Pankhurst NW, Porter MJR (2003) Cold and dark or warm and light: variations on the theme of environmental control of reproduction. Fish Physiol Biochem 28:385–389
Person-Le Ruyet J, Mahé K, Le Bayon N, Le Delliu H (2004) Effects of temperature on growth and metabolism in a Mediterranean population of European sea bass, Dicentrarchus labrax. Aquaculture 237:269–280
Pickering AD (1986) Changes in blood cells composition of the brown trout, Salmo trutta L., during spawning season. J Fish Biol 29:335–347
Pickering AD, Christie P (1981) Changes in the concentrations of plasma cortisol and thyroxine during sexual maturation of the hatchery-reared brown trout, Salmo trutta L. Gen Comp Endocrinol 44:487–496
Pierson PM, Lamers A, Flik G, Mayer-Gostan N (2004) The stress axis, stanniocalcin, and ion balance in rainbow trout. Gen Comp Endocrinol 137:263–271
Pololi-Anagnostou L, Schade S, Anagnostou A (1981) The effect of estrogens on erythroid stem cells in polycythemic mice. Mol Cell Endocrinol 24(1):73–84
Pulsford AL, Lemaire-Gony S, Tomlinson M, Collingwood N, Glynn PJ (1994) Effects of acute stress on the immune system of the dab, Limanda limanda. Comp Biochem Physiol 109C:129–139
Rodak BF (1992) Routine laboratory evaluation of erythrocytes. In: Lotspeich-Steininger CA, Stiene-Martin EA, Koepke JA (eds) Clinical haematology: principles, procedures, correlations. Lippincott, USA, pp 107–125
Rouff R, Rensing L (2004) Temperature effects on circadian clocks. J Therm Biol 29:445–456
Saha NL, Usami T, Suzuki Y (2004) In vitro effects of steroid hormones on IgM-secreting cells and IgM secretion in common carp (Cyprinus carpio). Fish Shellfish Immunol 17:149–158
Silveira-Coffigny R, Prieto-Trujillo A, Ascencio-Valle F (2004) Effects of different stressors in haematological variables in cultured Oreochromis aureus S. Comp Biochem Physiol 139(C):245–250
Slater CH, Schreck CB (1993) Testosterone alters the immune response of Chinook Salmon, Oncorhynchus tshawytscha. Gen Comp Endocrinol 89:291–298
Slater CH, Fitzpatrick MS, Schreck CB (1995) Characterization of an androgen receptor in salmonid lymphocytes: possible link to androgen–induced immunosuppression. Gen Comp Endocrinol 100:218–225
Sumpter JP (1997) Environmental control of fish reproduction: a different perspective. Fish Physiol Biochem 17:25–31
Takafumi Y, Watanuki H, Sakai M (2001) Effects of estradiol, progesterone and testosterone on the function of carp, Cyprinus carpio, phagocytes in vitro. Comp Biochem Physiol 129:49–55
Valenzuela AE, Silva VM, Klempau AE (2006a) Qualitative and quantitative effects of constant light photoperiod on rainbow trout (Oncorhynchus mykiss) peripheral blood erythrocytes. Aquaculture 251(2–4):596–602
Valenzuela AE, Silva VM, Klempau AE (2006b) Effects of constant light on haematological parameters of cultured rainbow trout (Oncorhynchus mykiss) in the southern hemisphere. Fish Physiol Biochem 32:113–120
Vanecek J (1998) Cellular mechanisms of melatonin action. Physiol Rev 78(3):687–711
Wedemeyer GA, Barton BA, McLeay DJ (1990) Stress and acclimation. In: Schreck CB, Moyle PB (eds) Methods for fish biology. Bethesda, MD, American Fisheries Society, pp 451–489
Wiik R, Andersen K, Uglenes I, Egidius E (1989) Cortisol-induced increased in susceptibility of Atlantic salmon together with effects on the blood cell pattern. Aquaculture 83:201–215
Wira C, Fahey JV, Abrahams VM, Rossoll RM (2003) Influence of stage of the reproductive cycle and estradiol on thymus cell antigen presentation. J Steroid Biochem Mol Biol 84:79–87
Witt-Enderby PA, Bennett J, Jarzynka MJ, Firestine S, Melan MA (2003) Melatonin receptors and their regulation: biochemical and structural mechanisms. Life Sci 72:2183–2198
Wojtaszek J, Dziewulska-Szwajkowska D, Lozinska-Gabska M, Adamowicz A, Dzugaj A (2002) Hematological effects of high dose of cortisol on the carp (Cyprinus carpio L.): Cortisol effect on the carp blood. Gen Comp Endocrinol 125:176–183
Yellon SM, Fagoaga OR, Nehlsen-Cannarella SL (1999) Influence of photoperiod on immune cell functions in the male Siberian hamster. Am J Physiol 276:R97–R102
Zapata G, Varas A, Torroba M (1992) Seasonal variations in the immune system of lower vertebrates. Immunol Today 13(4):142–147
Author information
Authors and Affiliations
Corresponding author
Rights and permissions
About this article
Cite this article
Valenzuela, A.E., Silva, V.M. & Klempau, A.E. Some changes in the haematological parameters of rainbow trout (Oncorhynchus mykiss) exposed to three artificial photoperiod regimes. Fish Physiol Biochem 33, 35–48 (2007). https://doi.org/10.1007/s10695-006-9115-4
Received:
Accepted:
Published:
Issue Date:
DOI: https://doi.org/10.1007/s10695-006-9115-4




